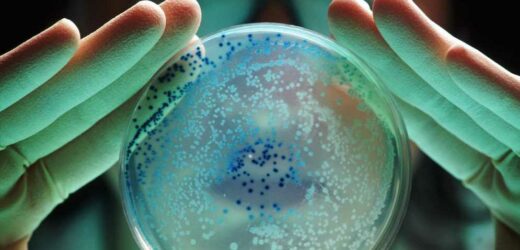

E.COLI is a type of bacteria that can cause food poisoning or serious infection.
Hundreds of residents across Surrey and Kent may be affected by the bacteria – with it in their drinking water.
The problem was found during routine tests, SES Water said.
Teams are now working around the clock to investigate and make sure all supplies have no trace of E. coli.
Homes in Redhill, Oxted, Limpsfield, Godstone and Sevenoaks are all thought to be affected.
Residents in those spots have been told to boil their tap water to ensure it is safe to drink – and also give cooled boiled water to their pets.
Some strand of the bacteria are deadly, but what type of strands of Escherichia coli are there, and how is it spread? Here's what you should know.
What is E.coli?
Escherichia coli is a type of bacteria common in human and animal intestines.
While most types of E.coli are harmless some can cause serious food poisoning and infection.
E.coli bacteria is a common cause of cystitis – an infection of the bladder.
Some types of E.coli can cause gastrointestinal infections.
As the bacteria can survive outside of the body, its levels serve as a measure of general hygiene and faecal contamination of an environment.
A common mode of infection is by eating food that is contaminated with the bacteria.
What are the symptoms of infection?
Some E.coli strains produce toxins (Shiga toxins) that can cause severe illness.
One common strain called E.coli 0157 produces such toxins and is usually responsible for the outbreaks that are covered by the news.
Classic symptoms linked to this strain, that include severe stomach cramps, vomiting, and diarrhoea that may be bloody.
The symptoms usually last up to seven days if there are no complications, but some infections can be severe and may be life-threatening.
A particular life-threatening complication called haemolytic uremic syndrome (HUS) may develop in 5-10 per cent of people infected with a toxin-producing form of E.coli.
This is a severe kidney-related complication that may, in extreme cases, lead to renal failure and the need for renal replacement therapy.
Two children from the same family died after contracting E.coli in Charnwood, Leicestershire before health bosses confirmed their deaths on 4 October.
Public Health England revealed it's working with environmental health officers after two cases of hemolytic uremic syndrome were confirmed in the siblings.
Can E.coli be spread through uncooked chicken?
E. coli infections can be serious so preventing infections is important.
The bacteria are usually spread through faecal matter reaching the mouth, so good hygiene is critical in preventing contamination and spread.
Handling or preparing food is a common source of infection.
Foods should be cooked thoroughly — and this includes chicken.
However, uncooked chicken is more likely to infect you with salmonella.
A study in 2017 found two in three fresh chickens sold in the UK is infected with E.coli.
However, the strain of the bacteria found in the meat is not dangerous to your health.
But experts said they fear it could live in the gut for years and cause resistance to antibiotics.
How is e.coli treated?
There are a number of different types of e.coli – most of which are harmless – but because of this there is no one treatment.
In some cases a short course of antibiotics may be necessary, according to the NHS website.
Intestinal infections are not normally treated with antibiotics.
Rehydration is important as fluids can be lost through diarrhoea.
Source: Read Full Article